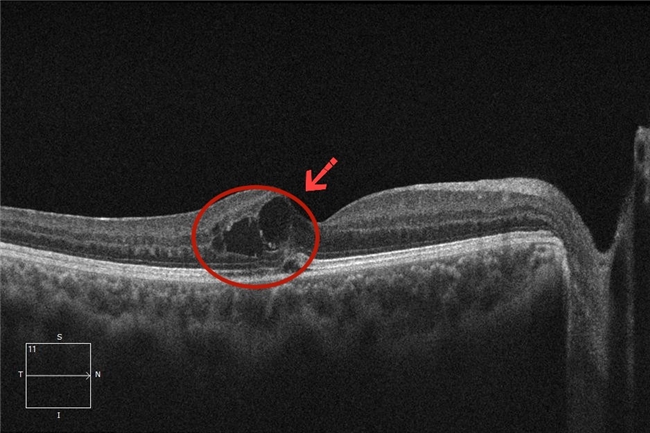

2025年12月,中银消费金融开展“金融知识进乡村 守护权益暖民心”专项教育宣传活动,各机构深入村落市集、田间地头、企业学校,实现金融教育广泛覆盖与精准触达。
12月25日当天,在上海奉贤区金王村,中银消费金融联动当地村党支部打造了一场特色活动。工作人员带着反诈漫画宣传册走进党群服务中心,生动的卡通形象将专业防骗知识转化为易懂的图画故事,引得村民们争相翻阅。活动现场,村民们一边跟着志愿者学反诈口诀,一边动手包汤团,有村民打趣道,这是把防骗“秘诀”和理财“妙招”包进了脑子里。这场融合乡村习俗与金融知识的活动,让生涩的专业内容变得鲜活,切实提升了村民尤其是老年群体的风险防范能力。
此外,中银消费金融还在安徽、浙江、河南、山东、四川等地的乡村、园区开展多样宣传活动,通过设立流动宣传点、携手党群服务中心等方式,将防范非法集资、电信诈骗、银行卡安全使用等知识送到群众身边,以接地气的形式筑牢乡村金融安全防线。